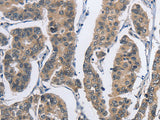
DSG2 Polyclonal Antibody Store at -20°C

DSG2 Polyclonal Antibody Store at -20°C
SKU: E-AB-11155-200
DSG2 Polyclonal Antibody Store at -20°C
| SKU # | E-AB-11155 |
| Reactivity | Human |
| Host | Rabbit |
| Applications | IHC |
Product Details
| Isotype | IgG |
| Host | Rabbit |
| Reactivity | Human |
| Applications | IHC |
| Clonality | Polyclonal |
| Immunogen | Recombinant protein of human DSG2 |
| Abbre | DSG2 |
| Synonyms | ARVC 10, ARVC10, ARVD 10, ARVD10, CDHF 5, CDHF5, CMD1BB, Cadherin family member 5, DSG 2, DSG2, Desmoglein 2, Desmoglein-2, Desmoglein2, HDGC, HDGC included, Human Desmoglein colon, MGC117034, MGC117036, MGC117037 |
| Swissprot | |
| Cellular Localization | Cell membrane. Cell junction>desmosome. |
| Concentration | 0.6 mg/mL |
| Buffer | Phosphate buffered solution, pH 7.4, containing 0.05% stabilizer and 50% glycerol. |
| Purification Method | Affinity purification |
| Research Areas | Cancer, Cardiovascular, Signal Transduction |
| Conjugation | Unconjugated |
| Storage | Store at -20°C Valid for 12 months. Avoid freeze / thaw cycles. |
| Shipping | The product is shipped with ice pack,upon receipt,store it immediately at the temperature recommended. |
Related Reagents
| Applications | Recommended Dilution |
| IHC | 1:50-1:200 |
Background
Desmosomes are cell-cell junctions between epithelial, myocardial, and certain other cell types. This gene product is a calcium-binding transmembrane glycoprotein component of desmosomes in vertebrate epithelial cells. Currently, three desmoglein subfamily members have been identified and all are members of the cadherin cell adhesion molecule superfamily. These desmoglein gene family members are located in a cluster on chromosome 18. This second family member is expressed in colon, colon carcinoma, and other simple and stratified epithelial-derived cell lines.